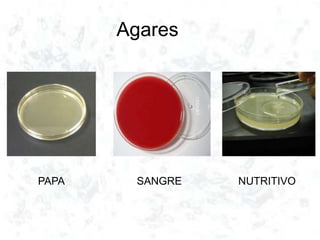
Agares
PAPA SANGRE NUTRITIVO
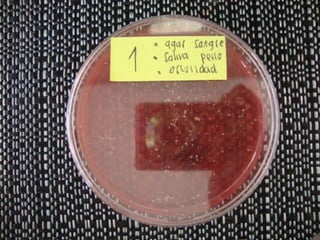
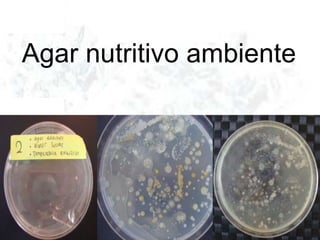
Agar nutritivo ambiente
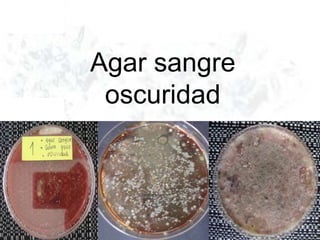
Agar sangre
oscuridad
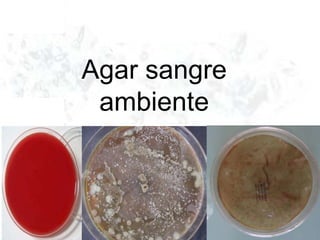
Agar sangre
ambiente
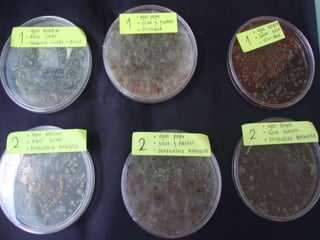
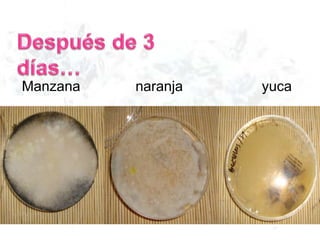
Manzana naranja yuca

Incrustar presentación
Descargar para leer sin conexión


































Este documento describe diferentes tipos de agar para cultivar bacterias y hongos, incluyendo agar nutritivo, agar de papa y agar de sangre, los cuales se probaron en condiciones de oscuridad y ambiente. También menciona algunos alimentos como manzanas, naranjas, yuca, pan y queso.